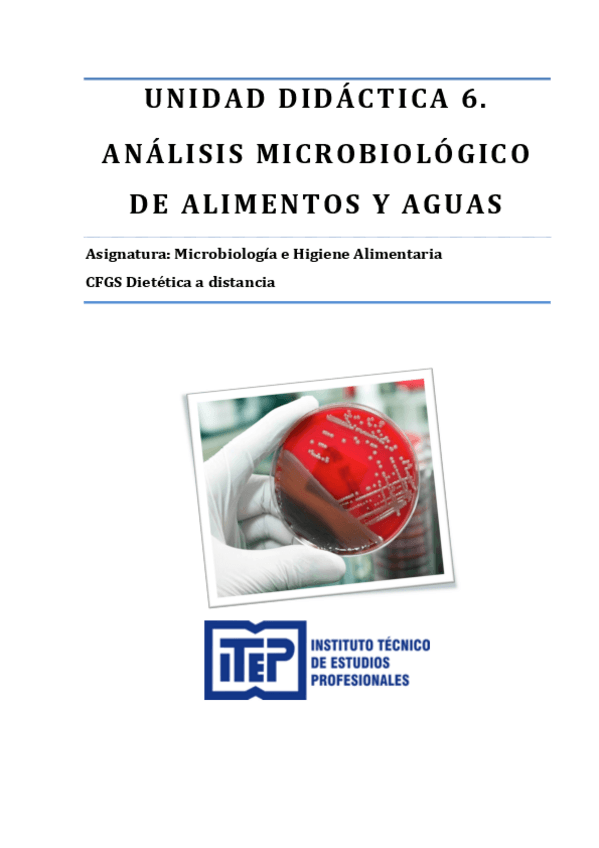

Microbiología y Parasitología
Todo
Apuntes
chevron_left
chevron_right
apuntes
-
Microbiología
He publicado nuevos apuntes de 2º Microbiología y Parasitología: Microbiología
apuntes
-
APUNTES ITEP
He publicado nuevos apuntes de 2º Microbiología y Parasitología: APUNTES ITEP
apuntes
-
Microbiología apuntes Temas 1-5
He publicado nuevos apuntes de 2º Microbiología y Parasitología: Microbiología apuntes Temas 1-5

¡Estás al día!
Has visto todos los archivos